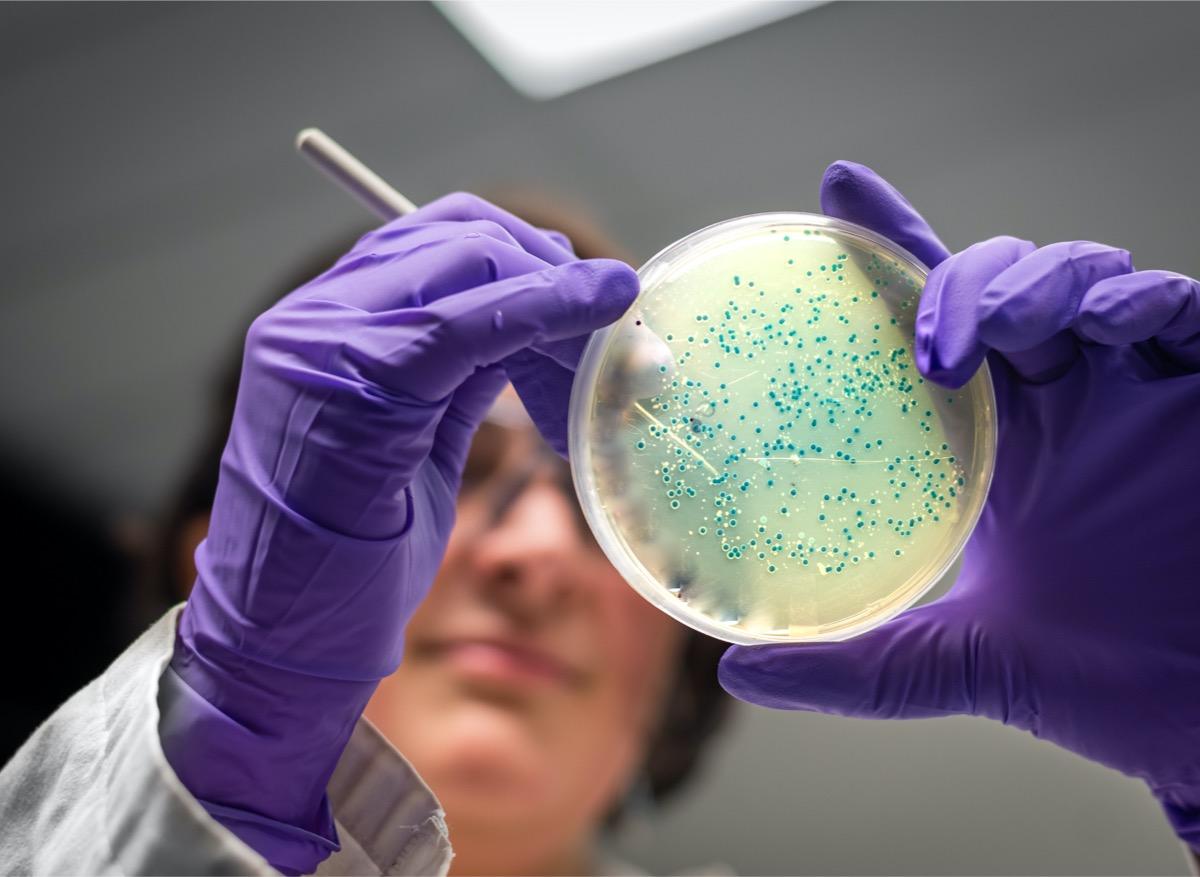

- Cet hydrogel permet à la fois de prévenir et de traiter les infections.
- Face à l’antibiorésistance, le risque principal est l’impasse thérapeutique : les antibiotiques ne sont plus efficaces contre ces bactéries résistantes, et il n’y a plus de traitement possible.
- D’après le Centre européen de prévention et de contrôle des maladies, plus de 5 000 décès sont liés à des infections par des bactéries résistantes chaque année, en France.
C’est un nouveau pansement révolutionnaire : un hydrogel de quelques millimètres d’épaisseur pour protéger les plaies des bactéries. Il a été mis au point par des chercheurs du Chalmers University of Technology, situé en Suède. Les détails de la conception de ce matériau sont publiés dans ACS Biomaterials Science & Engineering. "Après avoir testé notre hydrogel sur différents types de bactéries, nous avons constaté un niveau d’efficacité très élevé", se félicite Martin Andersson, l’auteur principal de cette recherche. Le matériau est même efficace contre les bactéries résistantes aux antibiotiques.
Un hydrogel sans danger pour la peau
Cela fait plusieurs années que des scientifiques travaillent sur le développement de cet hydrogel au sein de cette université. Au départ, l’objectif de ces recherches est de mettre au point une solution alternative aux antibiotiques. Le matériau contient des peptides anti-microbiennes, ce sont de petites protéines naturellement présentes dans notre système immunitaire. "Il y a très peu de risques que les bactéries développent une résistance face à elles, dans la mesure où elles affectent uniquement la partie externe de la bactérie", souligne le chercheur suédois. Il a fallu plusieurs années de recherches pour trouver une manière d’utiliser les peptides sans les abîmer : lorsqu’elles sont en contact avec du liquide, comme le sang, elles se dégradent. Martin Andersson et son équipe utilisent un hydrogel, car il permet de lier les peptides entre elles à l’intérieur ce qui les protège du liquide. "Ce matériau est très prometteur, ajoute Edvin Blomstrand, co-auteur. Il est sans danger pour les cellules humaines et non-agressif pour la peau." D’autres études cliniques sont en cours pour valider son utilisation. Il pourrait obtenir le marquage CE dès 2022, ce qui autoriserait sa commercialisation dans l’espace européen.
New material can protect against resistant bacteria. Researchers at Chalmers University have developed a new material – a specially designed hydrogel, that works against all types of bacteria, including antibiotic-resistant ones. #antibiotics https://t.co/oY6Us9vClu pic.twitter.com/QP2zOMTNMz
— Chalmers University (@chalmersuniv) May 11, 2021
Un outil dans la lutte contre l’antibiorésistance ?
Ce nouveau matériau pourrait être un outil précieux dans la lutte contre la résistance aux antibiotiques. Cette dernière a été classée parmi les menaces les plus graves pesant sur la santé mondiale par l’Organisation mondiale de la santé. Elle est liée aux mutations des bactéries, qui deviennent résistantes aux antibiotiques, suite à une mauvaise utilisation et/ou une surconsommation de ces derniers. "Il faut d’urgence changer dans le monde entier la façon dont nous prescrivons et utilisons ces médicaments, indique l’OMS sur son site. Même si l’on met au point de nouveaux antibiotiques, la résistance demeurera une grave menace sans une modification des comportements." Elle appelle notamment à réduire la propagation des infections grâce à la vaccination et aux lavages des mains.